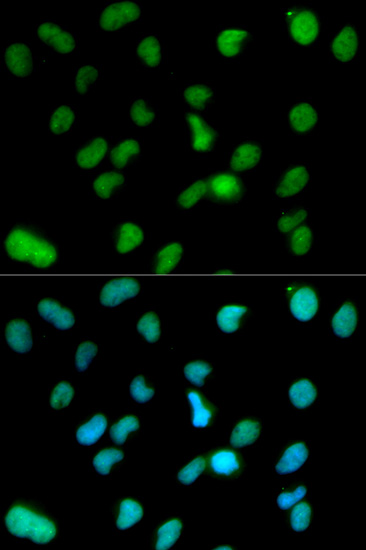

For quotations, please use our online quotation form, and you may also contact us by
service@kendallscientific.com
+1-888.733.6849 (Toll-free)
+1-617.299.7367 (Int’l))
+1-888.733.6849
Our customer service representatives are available 24 hours, Monday through Friday to assist you.| Reactivity | Human Mouse Rat |
| Tested applications | WB IHC IF IP ChIP |
| Recommended Dilution | WB 1:500 - 1:2000 IHC 1:50 - 1:200 IF 1:50 - 1:200 IP 1:50 - 1:200 ChIP 1:20 - 1:100 |
| Calculated MW | 95kDa |
| Observed MW | Refer to Figures |
| Immunogen | Recombinant protein of human KDM1A |
| Storage Buffer | Store at -20℃. Avoid freeze / thaw cycles. Buffer: PBS with 0.02% sodium azide, 50% glycerol, pH7.3. |
| Concentration | f |
| Synonym | KDM1;AOF2;BHC110;KIAA0601;LSD1 ; KDM1A |

Western blot analysis of extracts of various cell lysates using KDM1A antibody.

Immunohistochemistry of paraffin-embedded rat kidney using KDM1A antibody at dilution of 1:100 (x400 lens).
Immunofluorescence analysis of HeLa cell using KDM1A antibody. Blue: DAPI for nuclear staining.

Immunofluorescence analysis of A549 cell using KDM1A antibody.
Lysine-specific demethylase 1 (LSD1; also known as AOF2 and BHC110) is a nuclear amine oxidase homolog that acts as a histone demethylase and transcription cofactor (1). Gene activation and repression is specifically regulated by the methylation state of distinct histone protein lysine residues. For example, methylation of histone H3 at Lys4 facilitates transcriptional activation by coordinating the recruitment of BPTF, a component of the NURF chromatin remodeling complex, and WDR5, a component of multiple histone methyltransferase complexes (2,3). In contrast, methylation of histone H3 at Lys9 facilitates transcriptional repression by recruiting HP1 (4,5). LSD1 is a component of the CoREST transcriptional co-repressor complex that also contains CoREST, CtBP, HDAC1 and HDAC2. As part of this complex, LSD1 demethylates mono-methyl and di-methyl histone H3 at Lys4 through a FAD-dependent oxidation reaction to facilitate neuronal-specific gene repression in non-neuronal cells (1,6,7). In contrast, LSD1 associates with androgen receptor in human prostate cells to demethylate mono-methyl and di-methyl histone H3 at Lys9 and facilitate androgen receptor-dependent transcriptional activation (8). Therefore, depending on gene context LSD1 can function as either a transcriptional co-repressor or co-activator. LSD1 activity is inhibited by the amine oxidase inhibitors pargyline, deprenyl, clorgyline and tranylcypromine (8).
N/A